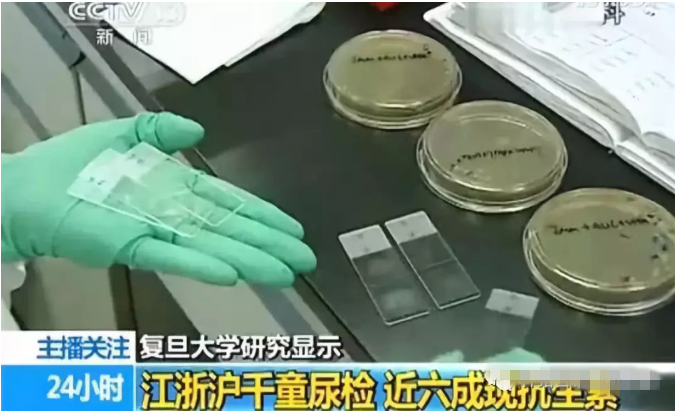
editor_1534558300542363.png 4.png

在近期,央视曝光了这样一则让人惊叹的数据:江浙沪竟有六成儿童体内检出兽用抗生素!
从1929年,弗莱明发现了青霉素,到1942年,青霉素大规模使用。 抗生素的出现帮人类解决了很多问题,但是问题也随之而来。疫苗问题还未平息,抗生素问题又祸起江浙沪。又一个周末,家长圈又被“抗生素问题”视频刷爆,曾经你微笑地喝着牛奶,愉快地啃着猪蹄或鸡腿,那是我们最幸福的时刻,但有一天检测你的血液,竟然流淌着兽用抗生素,我们为你精心烹饪的美食,结果竟然是伤害你的毒品…… 上海复旦大学公共卫生学院之前做的一项研究,这项研究针对江苏、浙江、上海1000多名8到11岁的在校儿童尿液进行检验,结果显示:近6成儿童检出尿液中含有抗生素。 1 检出畜禽用抗生素 化验结果表明,这1000个儿童中,至少有58%的儿童尿中检出一种抗生素,四分之一的儿童尿中检出2种以上抗生素,有的尿液样本中能检出6种抗生素。如果这类成分长期存在于体内,将对儿童的生长发育造成不良影响。这次监测还发现,金霉素、恩诺沙星、泰乐菌素等三种一般只限于畜禽使用的抗生素,在儿童体内均有检出。要知道恩诺沙星,泰乐菌素对支原体有特效的抗生素,但都是仅限于畜禽和水产专用的,怎么会到孩子体内呢? 2 环境食品或成暴露源 该课题组成员表示,他们研究发现,此次从这1000名江浙沪儿童体内检测出了临床上早已不推荐儿童中使用的抗生素成分,并且,这些抗生素成分在我们生活的环境和食品中也能经常发现。换言之,不仅是临床治疗,环境与食品也可能成为抗生素的重要暴露源。 该结果表明,我国儿童普遍暴露于低剂量抗生素。 3 吃肉,还是在“吃抗生素”? 根据《美国国家科学院院刊》上发表的一项研究,由于全球对肉类食品的需求急剧上升,在猪肉、牛肉和禽肉中的抗生素含量也在急剧飙升。 同样重量的猪肉要比牛肉多使用5倍的抗生素,比鸡肉多使用2倍,在我国,猪肉是主要的肉类食品。 卫生部合理用药专家委员会委员肖教授表示,抗生素遗留主要有两方面的原因。 一方面是农业养殖业。 在大量的圈养的畜禽养殖中,很多畜禽会生病,于是会大量的使用抗生素。 而另一方面是人为原因: 比如药品企业生产过程中的残留残渣,还有人们丢弃过期的药物,都会导致环境中抗生素成分残留。 通过食物链,层层递进,抗生素就这样光天化日侵入我们的体内。 所以,中国儿童抗生素的广泛暴露状态可能加重细菌耐药,从而威胁重要的临床治疗,也可能对儿童的生长发育与人群健康造成潜在的危害。 4 抗生素的滥用 抗生素是用于治疗各种细菌感染或抑制致病微生物感染的药物,在中国,抗生素的滥用尤其严重。据统计,中国人平均每人每年要挂8瓶盐水,远远高于国际上2.5~3.3瓶的水平,我国俨然已成“吊瓶大国”。 世卫组织曾多次警告,如果中国不控制抗生素滥用,将害了全世界。有关资料显示,中国是抗生素使用大国,也是抗生素生产大国:年产抗生素原料大约21万吨,出口3万吨,其余自用(包括医疗与农业使用),人均年消费量138克左右。 据2006-2007年度卫生部全国细菌耐药监测结果显示,全国医院抗菌药物年使用率高达74%。而世界上没有哪个国家如此大规模地使用抗生素,在美英等发达国家,医院的抗生素使用率仅为22%~25%。使用率超欧美三倍! 据1995-2007年疾病分类调查,中国感染性疾病占全部疾病总发病数的49%,其中细菌感染性占全部疾病的18%-21%,也就是说80%以上属于滥用抗生素,每年有8万人因此死亡。这些数字使中国成为世界上滥用抗生素问题最严重的国家之一。 在养殖业中,抗生素最初是用来预防动物疾病的,在使用过程中,一些饲养者把抗生素的发酵残渣加在饲料中喂猪,并发现用这种饲料比用普通饲料饲喂的仔猪长得更快。 Moore(1946)又发现,在鸡饲料中添加少量链霉素能促进雏鸡的生长发育。以后许多人又陆续发现金霉素、地霉素等对犊牛、猪和禽等均有促进生长发育和育肥的作用。 在上个世纪60年代前后,有许多抗生素品种相继问世并工业化生产,研究者们几乎对每个新问世的抗生素都作了以促进动物加速生长为目的的饲养试验。研究结果肯定了多种抗生素具有刺激和加速动物生长的作用。这个消息很快在世界各地传播开来,并引起各国的重视。 至此,抗生素作为畜禽饲料添加剂形成了一股极大的热潮,全世界范围内都开始使用,而且使用量日益增加。据估计,我国每年抗生素原料生产量约为21万吨,其中有9.7万吨的抗生素用于畜牧养殖业。 随着抗生素在饲料中长期大量使用,细菌耐药性和食品安全问题也引起了全球的普遍关注。 5 滥用抗生素危害知多少 滥用抗生素使病原菌产生耐药性细菌可通过三种方式获得耐药性,一是在细菌繁殖的二分裂阶段通过代与代之间进行传递。二是通过自发的基因突变产生。三是从附近其他的细菌细胞上获得耐药性基因。虽然耐药性因子的传递频率不高,但由于细菌数量大,繁殖快,仍易造成抗菌株的扩散蔓延。 抗生素滥用导致耐药菌株增加,而抗生素饲料添加剂长期大量不合理使用是主要原因。 美国《新闻周刊》报道,仅1992年美国就有13300名患者死于抗生素耐药性的细菌感染。 路透社1999年2月还报道了美国科学家在肉鸡饲料中发现超级细菌,这种肠球菌对目前所有的抗生素具有耐药性,超级细菌的产生给人类疾病的治疗带来极大的困难。 抗生素在机体内残留,影响人和动物的免疫和治疗效果 当机体摄入大量抗生素后,其跟随血液循环遍布人体多个器官组织中,如淋巴结、肾、肺、骨骼、肝、脾、胸腺等各组织器官,造成动物机体的免疫能力逐渐降低,使慢性疾病增多而且频发。 同时,抗生素还导致抗原质量降低,对疫苗接种产生不良影响,为控制疫病的发生埋下了隐患。抗生素在治疗人类疾病和畜禽疾病中的效果逐渐变差,为了起到治病效果,抗生素的用量也在不断增大,形成了恶性循环。 长期超量使用抗生素,还易产生致病菌的交叉感染。 使用抗生素,尤其是超量使用,会破坏肠道内的微生态平衡,一方面使胃肠道内对抗生素敏感性强的微生物减少,而敏感性差的菌群趁机大量繁殖,引起微生态失衡。 另一方面体内的微生物被抗生素消灭后,为体外微生物的侵入繁殖创造了条件,从而易产生致病的交叉感染。 上海复旦大学公共卫生学院的此项研究数据可能只是“冰山一角”,滥用抗生素带来的不仅是对你我个体身体健康的威胁,更是需要重视的公共卫生问题。 6 舌尖上的安全不容忽视 对此,农业部等部门高度重视,严格落实“四个最严”监管,坚持“产出来、管出来”两手抓、两手硬,多措并举,努力保障人民群众“舌尖上的安全”。 据悉,我国是养殖业大国,也是兽用抗菌药生产和使用大国。但是,当前兽用抗菌药市场秩序不够规范、饲料生产和养殖环节用药不尽合理、执行休药期规定不够严、安全用药意识不够强等问题突出,兽药残留监控和动物源细菌耐药性防控体系还比较薄弱,养殖环节兽药残留超标风险和细菌耐药风险形势依然严峻。 我国抗生素限制与欧美国家还有很大差距,积极完善相关法律法规依然是关键。 抗生素的发现无疑对人类的身体健康有巨大的保障和好处,但是由于抗菌药物的研发难度大,收益低,近年抗菌药物的发展相当慢,而耐药菌又不断出现给人类敲响了警钟。 以上这些,都说明了我们国家抗生素滥用的状况,抗生素一旦被滥用就会引起一些细菌和疾病的耐药性,这一切都是我们没有办法控制的,国外已经重视这种问题了,希望我们国家也可以严格的管理抗生素的使用,还国人一个健康的生活环境。 虽道阻且长,但行则将至。